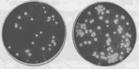
尿苷二磷酸

尿苷二磷酸

尿苷二磷酸-N-Z醯葡糖胺uridinedipho-sphateN-acetylglucosamine簡稱UDP-N-乙醯葡糖胺。系核苷酸糖的一種,抗體可用於ELISA檢測、Westernblot、免疫組織化學實驗,為UGP2的研究提供了有力的工具。
 尿苷二磷酸尿苷二磷酸-N-Z醯葡糖胺uridinedipho-sphateN-acetylglucosamine簡稱UDP-N-乙醯葡糖胺。系核苷酸糖的一種,由N-乙醯萄糖胺-1-磷酸和UTP生物合成。對於細菌細胞的肽葡聚糖(peptidoglycan)、酯多糖、黴菌的聚乙醯氨基葡糖、動物的透明質酸、肝素、糖蛋白、糖脂的生物合成可作為N-乙醯葡糖胺殘基的供體。此外,許多細胞具有UDP-N-乙醯葡糖胺-4-差向異構酶(UDP-N-acetylglucosamine-4-epim-erase,EC5.1.3.7)由於此酶的作用發生差向異構化反應,轉變為UDP-N-乙醯半乳糖胺,此生成物被利用於硫酸軟骨素、硫酸皮膚素、血型物質等糖蛋白的生物合成。
尿苷二磷酸尿苷二磷酸-N-Z醯葡糖胺uridinedipho-sphateN-acetylglucosamine簡稱UDP-N-乙醯葡糖胺。系核苷酸糖的一種,由N-乙醯萄糖胺-1-磷酸和UTP生物合成。對於細菌細胞的肽葡聚糖(peptidoglycan)、酯多糖、黴菌的聚乙醯氨基葡糖、動物的透明質酸、肝素、糖蛋白、糖脂的生物合成可作為N-乙醯葡糖胺殘基的供體。此外,許多細胞具有UDP-N-乙醯葡糖胺-4-差向異構酶(UDP-N-acetylglucosamine-4-epim-erase,EC5.1.3.7)由於此酶的作用發生差向異構化反應,轉變為UDP-N-乙醯半乳糖胺,此生成物被利用於硫酸軟骨素、硫酸皮膚素、血型物質等糖蛋白的生物合成。介紹
 尿苷二磷酸本研究製備抗人尿苷二磷酸葡萄糖焦磷酸化酶2(UDPglucosepyrophosphorylase2)的單克隆抗體(mAb)並進行初步鑑定。將正常成人肝組織勻漿離心並分離肝臟胞漿總蛋白,用肝臟胞漿總蛋白免疫BALB/c小鼠,採用雜交瘤技術製備單克隆抗體,通過間接ELISA法、Westernblot及免疫組織化學的方法對單克隆抗體進行特性鑑定,通過UniZAPXR肝臟cDNA表達文庫篩選鑑定抗體特異性。結果表明:通過間接ELISA篩選獲得1株可穩定分泌抗人UGP2mAb的雜交瘤細胞系BAD062,其分泌的單克隆抗體的Ig亞類(型)為IgG2b(κ),Westernblot結果顯示該抗體可以特異地識別分子量為56kD的蛋白;套用單克隆抗體BAD062對人肝臟cDNA表達文庫(UniZAPXR)進行篩選,陽性噬菌斑測序結果顯示2個陽性克隆插入序列均為UGP2。結論:單克隆抗體BAD062特異地識別抗原UGP2,該抗體可用於ELISA檢測、Westernblot、免疫組織化學實驗,為UGP2的研究提供了有力的工具。
尿苷二磷酸本研究製備抗人尿苷二磷酸葡萄糖焦磷酸化酶2(UDPglucosepyrophosphorylase2)的單克隆抗體(mAb)並進行初步鑑定。將正常成人肝組織勻漿離心並分離肝臟胞漿總蛋白,用肝臟胞漿總蛋白免疫BALB/c小鼠,採用雜交瘤技術製備單克隆抗體,通過間接ELISA法、Westernblot及免疫組織化學的方法對單克隆抗體進行特性鑑定,通過UniZAPXR肝臟cDNA表達文庫篩選鑑定抗體特異性。結果表明:通過間接ELISA篩選獲得1株可穩定分泌抗人UGP2mAb的雜交瘤細胞系BAD062,其分泌的單克隆抗體的Ig亞類(型)為IgG2b(κ),Westernblot結果顯示該抗體可以特異地識別分子量為56kD的蛋白;套用單克隆抗體BAD062對人肝臟cDNA表達文庫(UniZAPXR)進行篩選,陽性噬菌斑測序結果顯示2個陽性克隆插入序列均為UGP2。結論:單克隆抗體BAD062特異地識別抗原UGP2,該抗體可用於ELISA檢測、Westernblot、免疫組織化學實驗,為UGP2的研究提供了有力的工具。 尿苷二磷酸
尿苷二磷酸 尿苷二磷酸
尿苷二磷酸
尿苷二磷酸
尿苷二磷酸 尿苷二磷酸
尿苷二磷酸